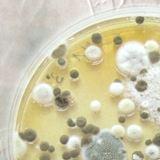

Gesundheit / Umwelt
Baubiologie
Definitionsgemäß ist Baubiologie die Lehre von den ganzheitlichen Beziehungen zwischen Wohn-Umwelt und Menschen.
Viele wissenschaftliche Tatsachen lassen die Folgen erkennen weiter lesen
Eine Einordnung verschiedenartiger Belastungsmöglichkeiten geben Hinweise zu möglichen Zusammenhängen:
SCHIMMELPILZE – Was ist das?
"Schimmelpilze" ist ein Sammelbegriff für Pilze, die typische Pilzfäden und Sporen ausbilden können. Schimmelpilze bilden in der Wachstumsphase Zellfäden. Diese sind meist farblos, so dass der Schimmelpilz in dieser Phase normalerweise mit dem bloßen Auge nicht erkennbar ist. Zur Vermehrung und Verbreitung bilden Schimmelpilze "Sporen". Diese sind oft gefärbt, so dass der Schimmelpilzbefall in diesem Stadium auch mit bloßem Auge (zum Beispiel als schwarze oder gelbe Schimmelpilzflecken) erkennbar ist.
PILZE / PARTIKEL / ALLERGENE
Zahlreiche Studien zu den gesundheitlichen Auswirkungen von Schimmelpilzen sehen einen Zusammenhang zwischen der Belastung mit Schimmelpilzen und Atemwegsbeschwerden. Sporen und Stoffwechselprodukte von Schimmelpilzen können, über die Luft eingeatmet, allergische und reizende Reaktionen beim Menschen auslösen.
In keiner dieser Studien konnte jedoch bislang festgestellt werden, ab welcher Konzentration an Schimmelpilzen in der Luft mit gesundheitlich negativen Auswirkungen gerechnet werden muss.
Es wird angenommen, dass grundsätzlich alle Schimmelpilze in der Lage sind, allergische Reaktionen bei dafür empfänglichen Personen auszulösen. Es kann dann zu allergischen Erscheinungen kommen, bei denen eine ganze Kette von Reaktionen im Körper abläuft, an deren Ende die typischen Symptome allergischer Reaktionen, wie Schnupfen, Niesen, gerötete Augen, Hautausschlag etc. stehen. Die häufigsten bei Schimmelpilzbelastungen im Innenraum beschriebenen Symptome sind unspezifisch, so zum Beispiel Bindehaut-, Hals- und Nasenreizungen sowie Husten, Kopfweh oder Müdigkeit.
Infektionen durch Schimmelpilze (Mykosen) kommen nur sehr selten und nur bei besonders empfänglichen, stark immungeschwächten Personen vor. Allergische und reizende Wirkungen können sowohl von lebenden als auch von abgestorbenen Schimmelpilzen ausgehen, während zur Auslösung von Infektionen nur lebende Schimmelpilze befähigt sind.
Bisher fand man keinen Kausalzusammenhang zwischen dem Auftreten von Schimmelbefall in Wohnungen und gesundheitlich negativen Wirkungen bei den Bewohnern.
Mitläufererscheinungen?
Bei "Schimmelpilzbefall" treten neben Schimmelpilzen oft auch Bakterien wie die Actinomyceten auf. Erste Untersuchungen haben gezeigt, dass die auftretenden Actinomyceten und Extrakte der befallenen Baumaterialien schädlich für lebende Zellen in Zellkulturen sein können.
Die ersten Untersuchungsergebnisse lassen keine Aussage darüber zu, wie die gesundheitliche Wirkung der Actinomyceten im Verhältnis zu den Schimmelpilzen zu beurteilen ist und wie die Risiken für den Menschen einzustufen sind.
Bei fachgerechter Schimmelpilzsanierung werden sowohl die Schimmelpilze als auch die Actinomyceten beseitigt.
WOHNGIFTE / SCHADSTOFFE
Von vielen aus gefährlichen Chemikalien hergestellten Baustoffen, Leimen und Oberflächenpräparaten aller Art werden gesundheitsschädliche Gase an die Raumluft abgegeben (z.B. PCP, PCB, Lindan, Formaldehyd); fast jedes Haus und jeder Mensch ist heute damit belastet.
Felder / Wellen / Strahlung
Bei einer baubiologischen Untersuchung verwandeln wir einen Raum fast in ein physikalisches Messlabor. Verschiedene Geräte lösen die unterschiedlichsten Messaufgaben: Elektrisch, magnetisch, radioaktiv, toxisch, mikrobiologisch ... , Spannung, Strom, Strahlung, Welle ... , Feldstärke, Dosis, Frequenz, Modulation ... Empfindliche Apparate brummen, Zeiger schlagen aus, Schreiber zeichnen auf, Rechner zählen. Nicht Spürbares wird spürbar, nicht Hörbares wird hörbar, nicht Sichtbares wird sichtbar. Wissen ersetzt Glauben. Solide Information wird Grundlage für Entscheidungen und Veränderungen.
Stress bedeutet Druck, Belastung, Spannung. Die Stressfaktoren unserer Lebensräume sind mannigfaltig, die durch Strom und Strahlung im Altag besonders häufig. Es gibt kaum einen Schlafplatz, kaum einen der nicht durch mehr oder minder auffällige und zumeist völlig unnötige elektromagnetische Feldeinflüsse gestört wäre, teilweise derart extrem, dass im Bett Computerarbeitsplatznormen überschritten werden. Jede baubiologische Untersuchung fällt anders aus. Jeder Mensch ist und reagiert anders.
ergänzende Ausführungen
Viele wissenschaftliche Tatsachen lassen die Folgen erkennen, die sich aus dem Ignorieren baubiologischer Erkenntnisse ergeben: Anhand umfangreicher Tier- und Pflanzenversuche sowie durch Untersuchungen an Menschen wurde nachgewiesen, dass baubiologische Störungen zu allgemeinem Unwohlsein, seelisch-geistiger und körperlicher Erkrankung, Unfruchtbarkeit, Leistungsabfall, Degeneration und zu verminderter Lebenserwartung führen.
Von vielen aus gefährlichen Chemikalien hergestellten Baustoffen, Leimen und Oberflächenpräparaten aller Art werden gesundheitsschädliche Gase an die Raumluft abgegeben (z.B. PCP, PCB, Lindan, Formaldehyd); fast jedes Haus und jeder Mensch ist heute damit belastet.
In den meisten Wohnräumen, Schulen und Arbeitsstätten herrscht infolge der verbreiteten Verwendung von Kunststoffen, Kunstharzlacken etc. sowie wegen ungenügender Abschirmung elektrischer Leitungen und Geräte ein gesundheitlich bedenkliches elektrisches Reizklima (elektrische Aufladungen, elektrische Wechselfelder etc.). Dies führt zu einer dauernden stressartigen Belastung des Organismus, verbunden mit nervösen Beschwerden, Herzstörungen und Müdigkeit als Erstfolgen und häufig noch schwerwiegenderen Spätfolgen.
Zahlreiche Häuser sind auch durch lungengängige Fasern, Radongas, radioaktive Strahlung, Schimmelpilze etc. verseucht. Ungenügender Luftaustausch trägt ebenfalls zu einem schlechten Raumklima und damit zur Störung der Gesundheit bei.
In der Baubiologischen Messtechnik geht es um die messtechnischen Möglichkeiten und Grenzen einer zeitgemäßen Haus- und Arbeitsplatzuntersuchung. Grundlage ist der "Standard der baubiologischen Messtechnik". Im Mittelpunkt stehen die zahlreichen Risiken elektrischer, magnetischer und elektromagnetischer, radioaktiver und geologischer, chemischer, mikrobiologischer und raumklimatischer Art. Es geht um reproduzierbare und sachverständige Messungen in unseren Lebensräumen.